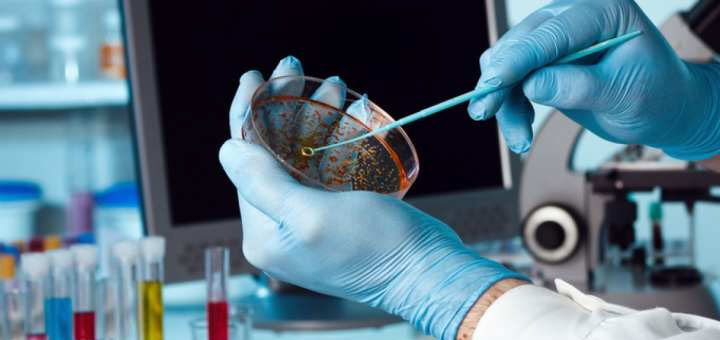

Agua de mar para crear combustible para aviones mediante la biología sintética

Investigadores de la Universidad de Mánchester en el Reino Unido están utilizando la biología sintética para explorar un camino más eficiente y confiable hacia la producción de combustibles para aviones.
Encontrar nuevas formas de reducir el impacto de la huella de carbono es probablemente el desafío más importante entre los científicos de la actualidad. Dirigido por el profesor Nigel Scrutton, director del Instituto de Biotecnología de Mánchester (MIB), y gracias a la financiación proporcionada por la Oficina Global de Investigación Científica de la Armada de los Estados Unidos (ONR Global), un grupo de investigadores de la Universidad de Mánchester está utilizando la biología sintética como plataforma para aprovechar la naturaleza a través de un camino mucho más eficiente y sostenible que el que se usa actualmente.

Los científicos descubrieron que una especie de bacteria llamada Halomonas, que crece en el agua de mar, crea un sostén microbiano fácil y viable que puede ser diseñado para producir compuestos de alto valor. La utilidad de tales plataformas de biología sintética es hacer productos químicos, que pueden explotarse como precursores del combustible para aviones. El proceso utilizado para obtener el combustible para aviones es limpio, barato y los recursos primarios para este sistema (es decir, agua de mar, azúcar) son abundantes. El proceso es similar al método empleado para elaborar cerveza, utilizando microbios para consumir azúcares/almidones (por ejemplo, desperdicio de alimentos) como fuente de energía.
El ingenio detrás de este enfoque es cómo los científicos pueden rediseñar el genoma del microbio para cambiar su metabolismo y crear diferentes tipos de compuestos químicos de alto valor, cuando normalmente pensamos en extraer petróleo crudo de la tierra, un proceso que no es sostenible y puede requerir mucha energía, antes de considerar el procesamiento químico sintético para producir compuestos químicos de valor. El Dr. Benjamin Harvey, científico jefe del Centro de Guerra Aérea Naval de China Lake en California, EE.UU., ha trabajado en la conversión de precursores biológicos en combustibles; de hecho, perfeccionó el sistema y ahora busca aprovechar esta colaboración exactamente para este propósito.
“Las estrategias efectivas de biocombustibles requieren la producción económica de combustibles derivados de un huésped microbiano robusto a gran escala, cultivados en biomasa de desechos renovables o corrientes de desechos industriales, con un procesamiento mínimo y evitando el uso de agua dulce. Con las Halomonas, estos requisitos se pueden cumplir, minimizando el gasto de capital y operativo en la producción de estos biocombustibles de última generación”, dice el profesor Nigel Scrutton, Director de MIB.
También es de interés para la Universidad de Mánchester la aplicabilidad de este proceso a diversas industrias, específicamente aquellas que dependen del petróleo crudo para generar una amplia gama de productos, como cosméticos, fragancias y sabores.
“Si se piensa en la extracción de aceite de rosa mosqueta; se necesita plantar cientos de hectáreas de flores y luego recoger las flores, exprimir el aceite de los pétalos de rosa para procesar pequeñas cantidades para hacer la fragancia. Es económicamente muy costoso, requiere mucha tierra y recursos, está sujeto al clima para la cosecha, cuando esos recursos podrían emplearse para una agricultura más sostenible”, declara Patrick Rose, Director Científico de ONR Global en Londres.
“Es posible replicar exactamente las mismas moléculas que cosechamos de los cultivos para hacer compuestos de alto valor al explotar este proceso biológico: sacar los genes de la planta e insertar la información en las bacterias. Con esta hazaña de ingeniería, no hay dependencia de factores ambientales y se logra un mayor nivel de confiabilidad en el producto”, concluye Rose.
El medioambiente
Aunque la industria química ha mejorado sus procesos de síntesis durante el siglo pasado, existen preocupaciones ambientales y económicas sobre la forma en que todavía se realiza la química. La ingeniería aplicada a bacterias para replicar los mismos procesos puede ser significativamente más sostenible, reducir los flujos de residuos, limitar la producción de subproductos tóxicos y no depende de recursos no sostenibles como el petróleo crudo. Lo innovador de esta plataforma desarrollada por el grupo de la Universidad de Mánchester es que las bacterias crecen en el agua de mar. La gestión del sistema y su durabilidad también son aspectos revolucionarios, con una vida útil muy larga para la producción continua.
“La biotecnología nos permite aprovechar la exquisita selectividad de la naturaleza para producir químicos complejos de manera eficiente, a menudo usando temperaturas y presiones más bajas que en la síntesis orgánica tradicional. Esto puede resultar en menos subproductos y contaminantes (es decir, trazas de metales de catalizadores), lo que simplifica la purificación y reduce los costos. En el caso de los derivados de combustible para aviones que estamos produciendo, son químicamente idénticos a las moléculas derivadas de petroquímicos, y podrán incorporarse a los procesos desarrollados en China Lake”, revela el Dr. Kirk Malone, Director de Comercialización de MIB.
La investigación podría ser una noticia innovadora para la industria más amplia de biocombustibles. A diferencia de los biocombustibles que conocemos hoy, que dependen de las tierras agrícolas para producir maíz y remolacha azucarera, la bioproducción en agua de mar evitaría preocupaciones éticas de «alimento o combustible». Además, los productos finales serían idénticos a los actuales, permitiendo a los automóviles mantener los mismos estándares de alto rendimiento sin tener que rediseñar el motor para consumir un producto de menor calidad.
La biología sintética está tomando principios de ingeniería y aplicándolos a la biología; un campo interdisciplinario en constante búsqueda del próximo descubrimiento revolucionario.
Fuente: Oficina Global de Investigación Científica de la Armada de los Estados Unidos








